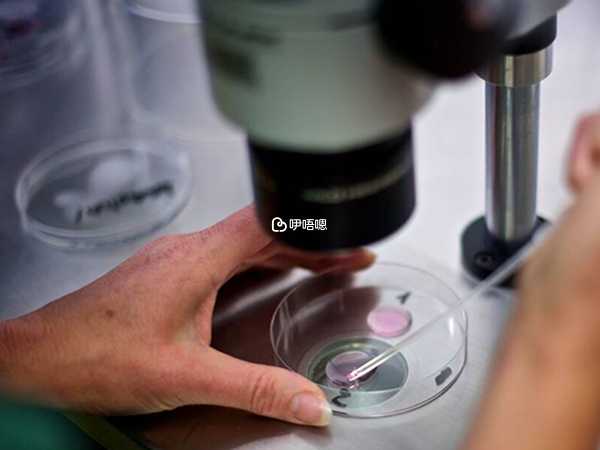

hiv即艾滋病毒,現在隨著艾滋病抗病毒治療的進步,艾滋病正在變得可控,患者的壽命延長,甚至與常人無異,那麼hiv患者可以生育後代嗎?現在試管嬰兒技術甚至可以幫助多種遺傳病患者生下健康的孩子,那試管嬰兒技術是否也可以幫助男性hiv感染者生下健康的孩子呢?
答案是肯定的!男性hiv(艾滋病)感染者也可以做試管嬰兒,生育健康寶寶,只是目前國內還達不到技術要求,相關規定說明也不能給男性hiv患者實施輔助生殖技術,需要到海外進行操作,如泰國、美國。
感染了艾滋病毒的人無法像普通人一樣通過自然受孕的方式來生育健康的寶寶,但是由於現在醫學及試管嬰兒技術的發展,通過洗滌精子技術男性hiv感染者也可以做試管嬰兒。
首先要知道,男性的精子是不攜帶hiv病毒的,hiv病毒是存在於精液中的。因此hiv 男性患者可以通過精子清洗技術將艾滋病毒與精子分離開來,從而阻隔hiv病毒向孕婦和胎兒傳播。

然後再經過三代試管嬰兒技術中PGD/PGS篩查技術,對胚胎進行檢測,雙重篩選下,以確保移植入子宮的是不攜帶hiv病原體的健康胚胎,實現生育健康寶寶的目標。
精子洗滌技術也被稱作洗精術,是藉助一些科學工具和手段,將健康乾淨的精子分離出來。在男性射出的正常的精液中,精子佔5%,精漿佔95%。
精漿是由附性腺的分泌液組成:其60%來源於精囊腺液,30%來源於前列腺液,含液化因子、鋅、枸櫞酸和酸性磷酸酶等成分,少量來自尿道球腺液和附睪液等。
針對男性hiv艾滋病患者生育,這裡用到的精子洗滌技術是梯度離心精子洗滌技術,離心技術能最大程度地維持精子的活性與質量。

在離心機的高度旋轉下精液會被分層,死精、細菌、病原體微生物等會浮在上面,精子則會沉澱在底部,這樣正常的精子就被有效分離出來了。
然後剔除精液,使用超敏感試驗對剩餘的精子樣本進行hiv檢測。如果沒有發現hiv病毒,則與卵子進行精卵結合。
基本資訊來自醫院官網或醫院內公示資訊或醫生本人提供,如有侵權,請按照平臺提供的渠道通知